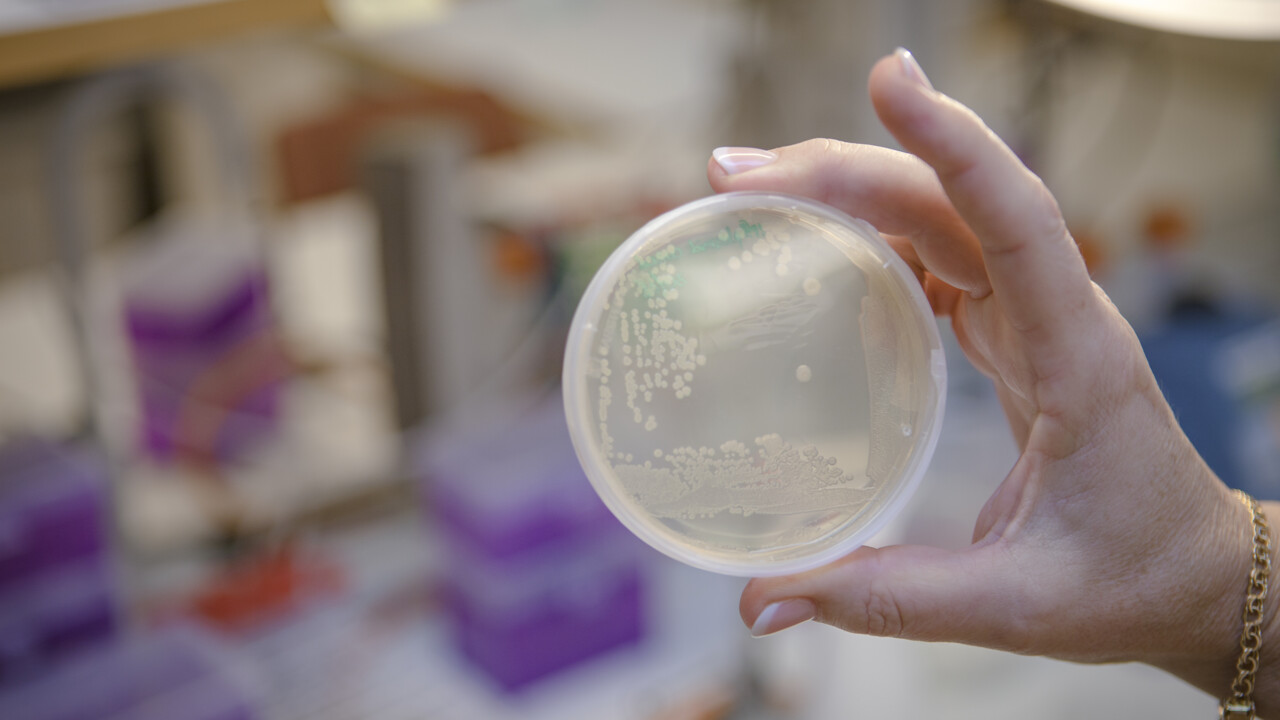
Bild på bakterieodling

FAKTA Om den vetenskapliga artikeln
Taylor M. Nye, Hasan Tükenmez, Pardeep Singh, Ana L. Flores-Mireles , Chloe L. P. Obernuefemann, Jerome S. Pinkner, Souvik Sarkar, Mari Bonde, Anders E. G. Lindgren, Karen W. Dodson, Jörgen Johansson, Fredrik Almqvist , Michael G. Caparon & Scott J. Hultgren (2022). Ring-fused 2-pyridones effective against multidrug-resistant Gram-positive pathogens and synergistic with standard-of-care antibiotics. Proceedings of the National Academy of Sciences of the United States of America, 119(43). https://www.pnas.org/doi/10.1073/pnas.2210912119